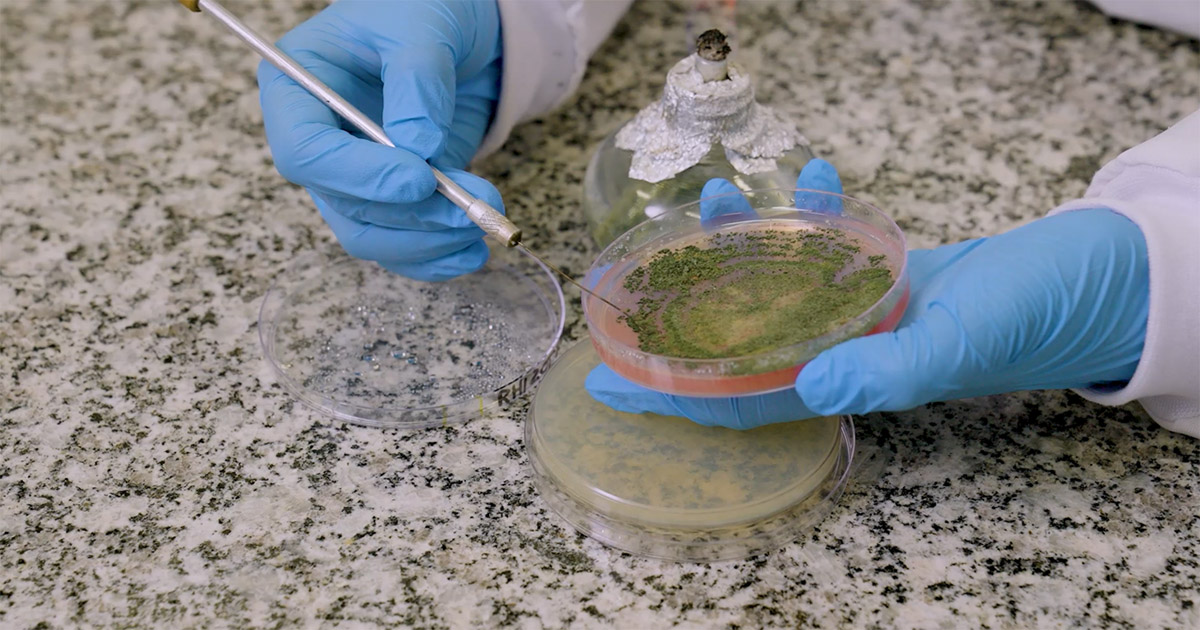

A demanda por insumos biológicos na agricultura vem ganhando força no Brasil e já reflete em uma tendência de crescimento ainda mais acelerado nos próximos anos. Mesmo em sua fase inicial, o mercado de bioinsumos cresce acima de 35% ao ano e já representa ao menos US$ 1,2 bilhão. A Biotrop dobra de tamanho a cada ano.
Este crescimento é impulsionado pelo avanço das pesquisas e desenvolvimento de novas soluções biológicas por parte das empresas, e pela maior adoção das tecnologias pelos produtores, convencidos dos benefícios em termos de produtividade, qualidade e ganhos ambientais, que advém do uso de bioinsumos.
O cenário promissor comprova que as novas tecnologias vão impulsionar o setor com combinações inovadoras. Entre os exemplos estão a associação de diferentes microrganismos no mesmo produto, metabólitos com ações biológicas pronunciadas e o uso de extratos de plantas em composições únicas.
Graças às novas tecnologias, já é possível também agregar novas funcionalidades às formulações dos produtos como, por exemplo, os polímeros que tratam sementes, que, além de atuar proporcionando adesão e recobrimento às sementes, hoje carregam um componente biológico que permite ação bionematicida, biofungicida, bioinseticida, ou de proteção frente estresses abióticos, como a seca. Bem-vindos à Era de insumos com múltiplas funções, com os Bioinsumos!
E há muito ainda a avançar. Cresce o desafio do manejo de problemas fitossanitários de difícil controle, que já têm resistência a produtos químicos. Esse problema pode ser mitigado pelo uso de produtos biológicos, que possuem múltiplos mecanismos de ação, evitando a seleção de pragas e daninhas resistentes, atuando assim, para a proteção a longo prazo das plantas.
A ciência também nos mostra que o manejo biológico funciona ainda melhor num ambiente de agricultura de precisão, e que analisa, além dos componentes químico e físico, o componente biológico do solo. É este o alvo do programa AGROBIOTA, que avalia a função biológica da microbiota do solo através de técnicas de genética, para entender suas necessidades, e indica o bioinsumo ideal para aquela cultura e área específica, de acordo com as condições ambientais presentes.
Os benefícios dos biológicos vão ainda além dos proveitos na agricultura. Os agricultores são favorecidos com o equilíbrio crescente na eficiência das culturas. O meio ambiente também agradece. Num tempo em que falamos muito em produção sustentável, os bionsumos são indispensáveis.
Já do ponto de vista econômico, ajudam os agricultores no planejamento de seus investimentos para a safra, visto que os biológicos são nacionais, com cotações mais estáveis. Assim, os produtores sentem-se mais seguros, sem a preocupação de grandes impactos no custo dos insumos com a flutuação do câmbio, por exemplo, que pode derrubar o retorno sobre a produção rapidamente.
Ainda com relação aos aspectos comerciais, está claro que o uso de biológicos abre portas para o mercado internacional, já que várias moléculas agroquímicas são proibidas em muitos países, principalmente no mercado europeu. Os bioinsumos, por sua vez, não têm restrição de uso e entram como alternativa eficaz na produção.
Portanto, sob esse prisma, os insumos biológicos são vantajosos para o bolso de quem planta, para a sociedade e para o planeta.
Este é o retrato da revolução em andamento, que tornará o Brasil ainda mais competitivo em termos globais. No caso específico, liderando o desenvolvimento e a utilização dos biológicos na produção agrícola.
Nesse cenário, a Biotrop, empresa nacional de soluções biológicas, tem planos arrojados para expansão dos seus negócios – tanto nacional como globalmente, ajudando a levar o nome do Brasil como exemplo de sucesso na adoção de Bioinsumos. Liderar a inovação no setor é apenas umas das frentes. Nosso ideal vai muito além disso, pois pensamos no sucesso dos nossos clientes e no que podemos fazer para contribuir ainda mais para um agronegócio melhor e mais seguro, que cresce com os olhos nas necessidades do consumidor final, que poderá desfrutar de alimentos mais saudáveis.
Por Juliana Marcolino Gomes, Mestre e Doutora em Genética e Biologia Molecular pela Universidade Estadual de Londrina (doutorado sanduíche pelo Plant Gene Expression Center – Albany, USA). Realizou Pós-doutorado na Embrapa Soja, atuando em projetos de pesquisa. Atualmente é gerente de Pesquisa e Inovação na Biotrop.